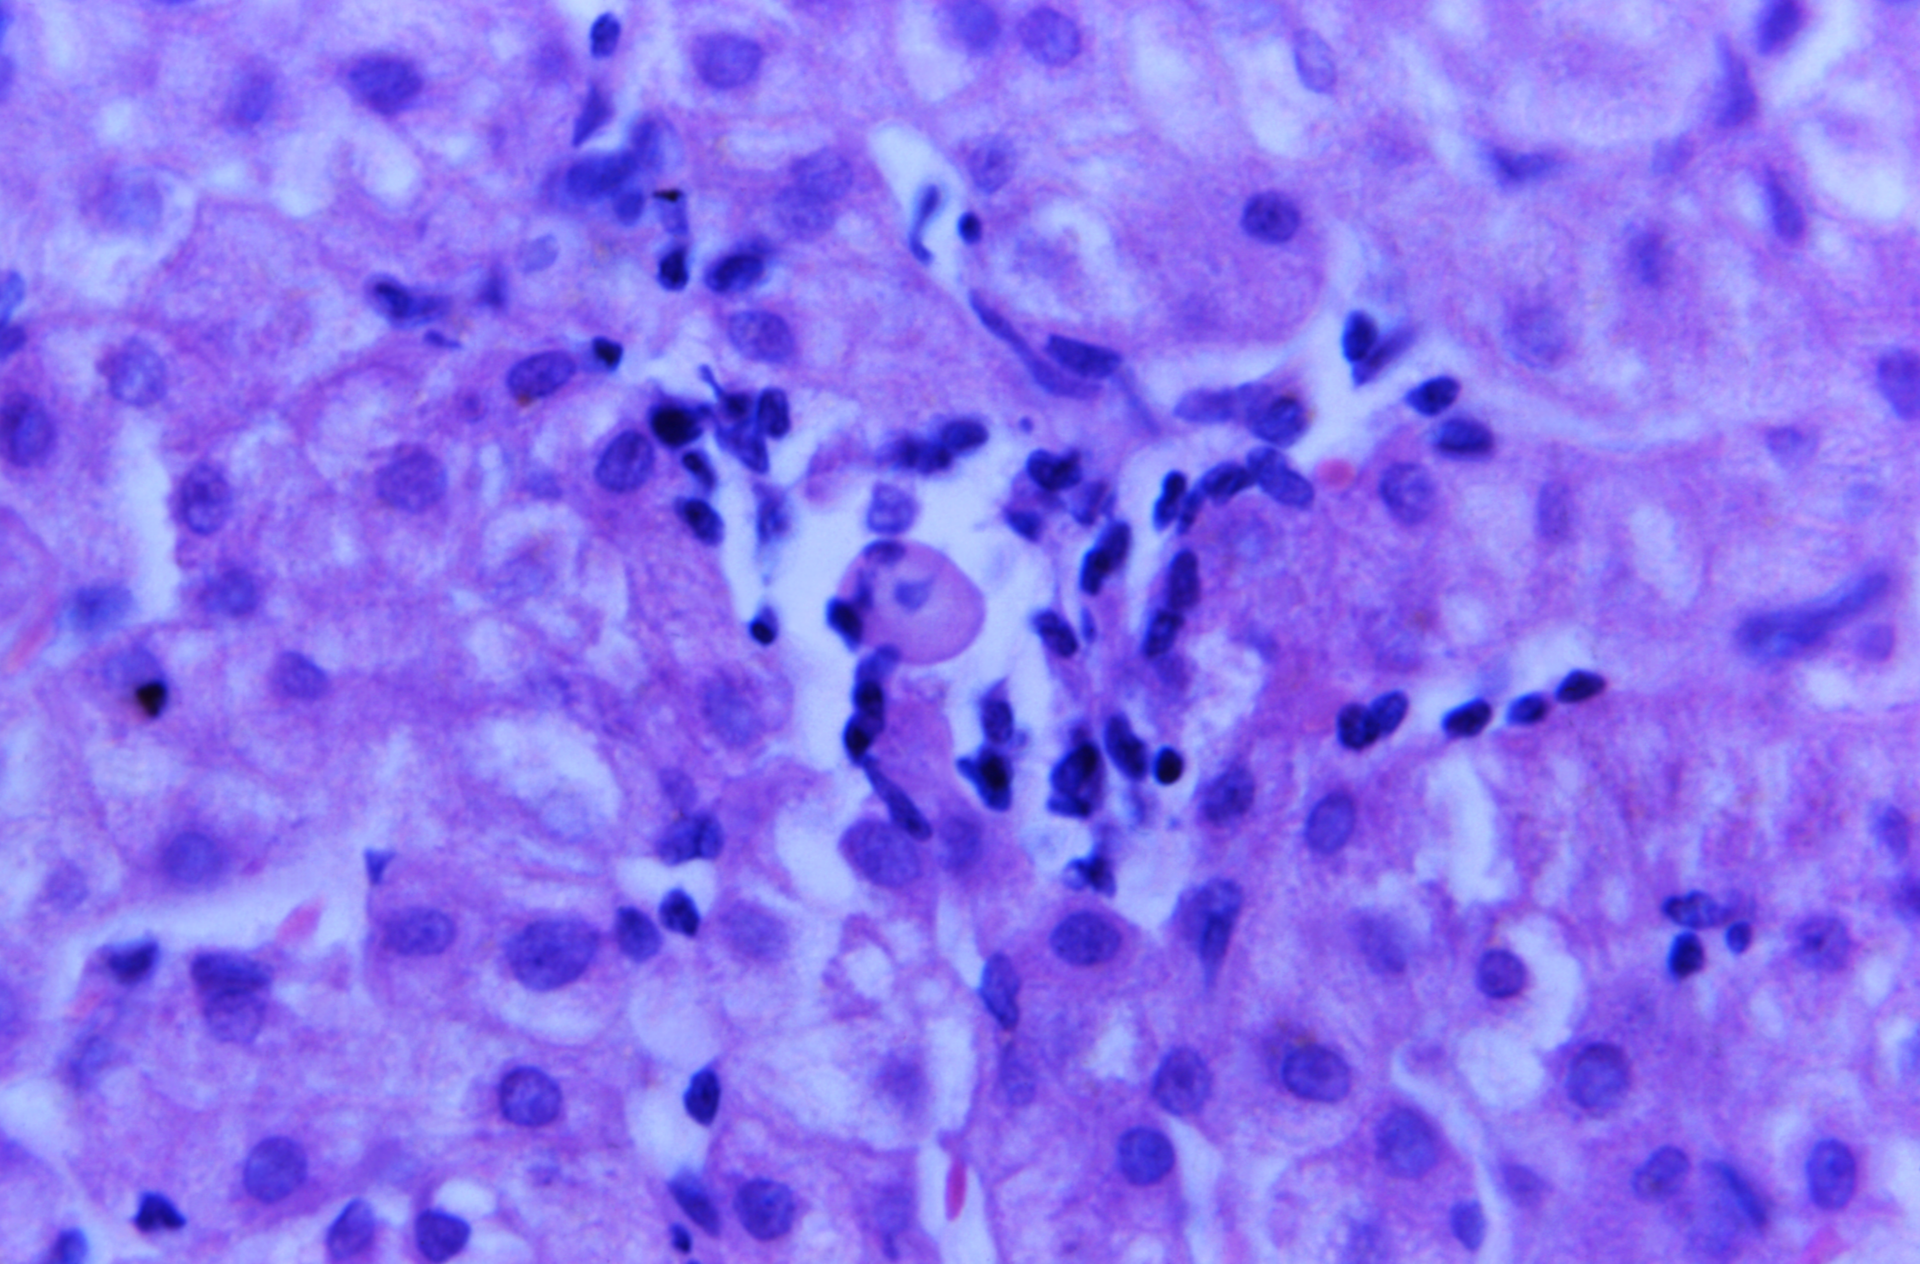
Courtesy of the CDC

CDC issues update on children hepatitis cases of unknown origin
The Centers for Disease Control and Prevention (CDC) is issuing a Health Alert Network (HAN) Health Update to provide clinicians and public health authorities with updated information about an epidemiologic investigation of pediatric cases of hepatitis of unknown etiology in the United States.
This investigation focuses on collecting information to describe the epidemiology, etiology, clinical presentation, severity, and risk factors related to illness and to identify any relationship between adenovirus infection or other factors and hepatitis. As of May 5, 2022, CDC and state partners are investigating 109 children with hepatitis of unknown origin across 25 states and territories, more than half of whom have tested positive for adenovirus with more than 90% hospitalized, 14% with liver transplants, and five deaths under investigation. Because this investigation is ongoing and includes reviewing cases of hepatitis of unknown cause with onset since October 2021, patients under investigation are not limited to current or newly diagnosed pediatric hepatitis illnesses.
This HAN Health Update also provides updated recommendations for testing specimens from patients under investigation. It is an update to a HAN Health Advisory that CDC issued on April 21, 2022, that initially notified clinicians and public health authorities of children identified with hepatitis of unknown origin and adenovirus infection.
A cluster of pediatric cases of hepatitis without an apparent etiology was identified and reported to CDC in November 2021. A possible association between pediatric hepatitis and adenovirus infection is under investigation after laboratory testing identified adenovirus infection in all nine patients in the initial cluster; the five specimens that could be typed were all adenovirus type 41. Investigators continue to examine the role of other possible causes and identify contributing factors.
Recommendations for Clinicians
- Clinicians should continue to follow standard practice for evaluating and managing patients with hepatitis of known and unknown etiology.
- Clinicians are recommended to consider adenovirus testing for patients with hepatitis of unknown etiology and to report such cases to their state or jurisdictional public health authorities.
- Because the potential relationship between adenovirus infection and hepatitis is still under investigation, clinicians should consider collecting the following specimen types if available from pediatric patients with hepatitis of unknown cause for adenovirus detection:
- Blood specimen collected in Ethylenediaminetetraacetic Acid (EDTA) (whole blood, plasma, or serum); whole blood is preferred to plasma and serum)
- Respiratory specimen (nasopharyngeal swab, sputum, or bronchioalveolar lavage [BAL])
- Stool specimen or rectal swab; a stool specimen is preferred to a rectal swab
- Liver tissue, if a biopsy was clinically indicated, or if tissue from native liver explant or autopsy is available:
- Formalin-fixed, paraffin embedded (FFPE) liver tissue
- Fresh liver tissue, frozen on dry ice or liquid nitrogen immediately or as soon as possible, and stored at ≤ -70°C
Nucleic acid amplification testing (NAAT), such as polymerase chain reaction (PCR), is preferred for adenovirus detection (currently not available for FFPE liver biopsy or native liver explant). Testing whole blood by PCR is more sensitive to and is preferred over testing plasma by PCR.
Where possible, clinical specimens should be tested locally to ensure timely results for patient care. For any diagnostic testing needs beyond the local capacity, CDC recommends that clinicians contact their state public health laboratory.